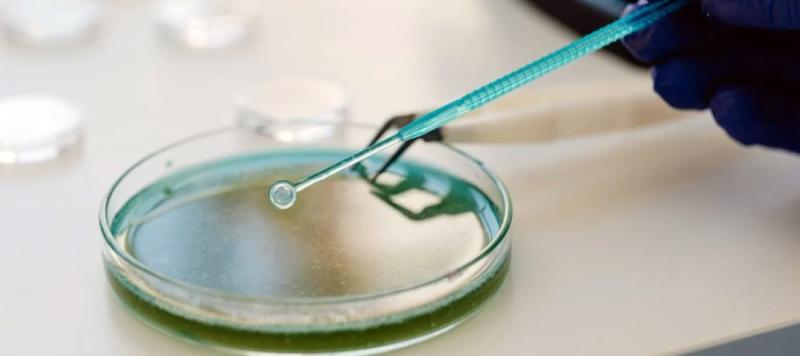

La microbiología alimentaria rápida volverá a ser protagonista en el "XXI Workshop Métodos rápidos y automatización en microbiología alimentaria", un clásico dentro de la docencia de esta disciplina en la UAB, que este año tendrá lugar del 21 al 24 de noviembre, en la Facultad de Veterinaria de la UAB de Bellaterra (Cerdanyola del Vallès).
Microbiología alimentaria, MRAMA
El "XX Workshop Métodos rápidos y automatización en microbiología alimentaria" está organizado, como en ediciones anteriores, por el Centre d'Innovació, Recerca i Transferència en Tecnologia dels Aliments (CIRTTA) y el Departament de Ciència Animal i dels Aliments de la UAB.
El evento contará con un amplio programa de ponencias, sesiones prácticas en laboratorio, exhibiciones de empresas y talleres.
Ponencias
Además de una visión general de los métodos y la automatización en microbiología alimentaria, en las 10 ponencias programadas se profundizará en temas diversos, como los métodos para contar las células viables, los métodos inmunológicos para detectar e identificar microorganismos y sus toxinas, o la polymerase chain reaction (PCR) y la secuenciación genómica masiva aplicadas a la seguridad alimentaria.
También tendrán un espacio temas de actualidad como los métodos de cultivo y moleculares para evaluar la calidad del agua potable, la cultura de la inocuidad alimentaria o tendencias de futuro en seguridad alimentaria.

Mas información en: https://webs.uab.cat/workshopmrama/